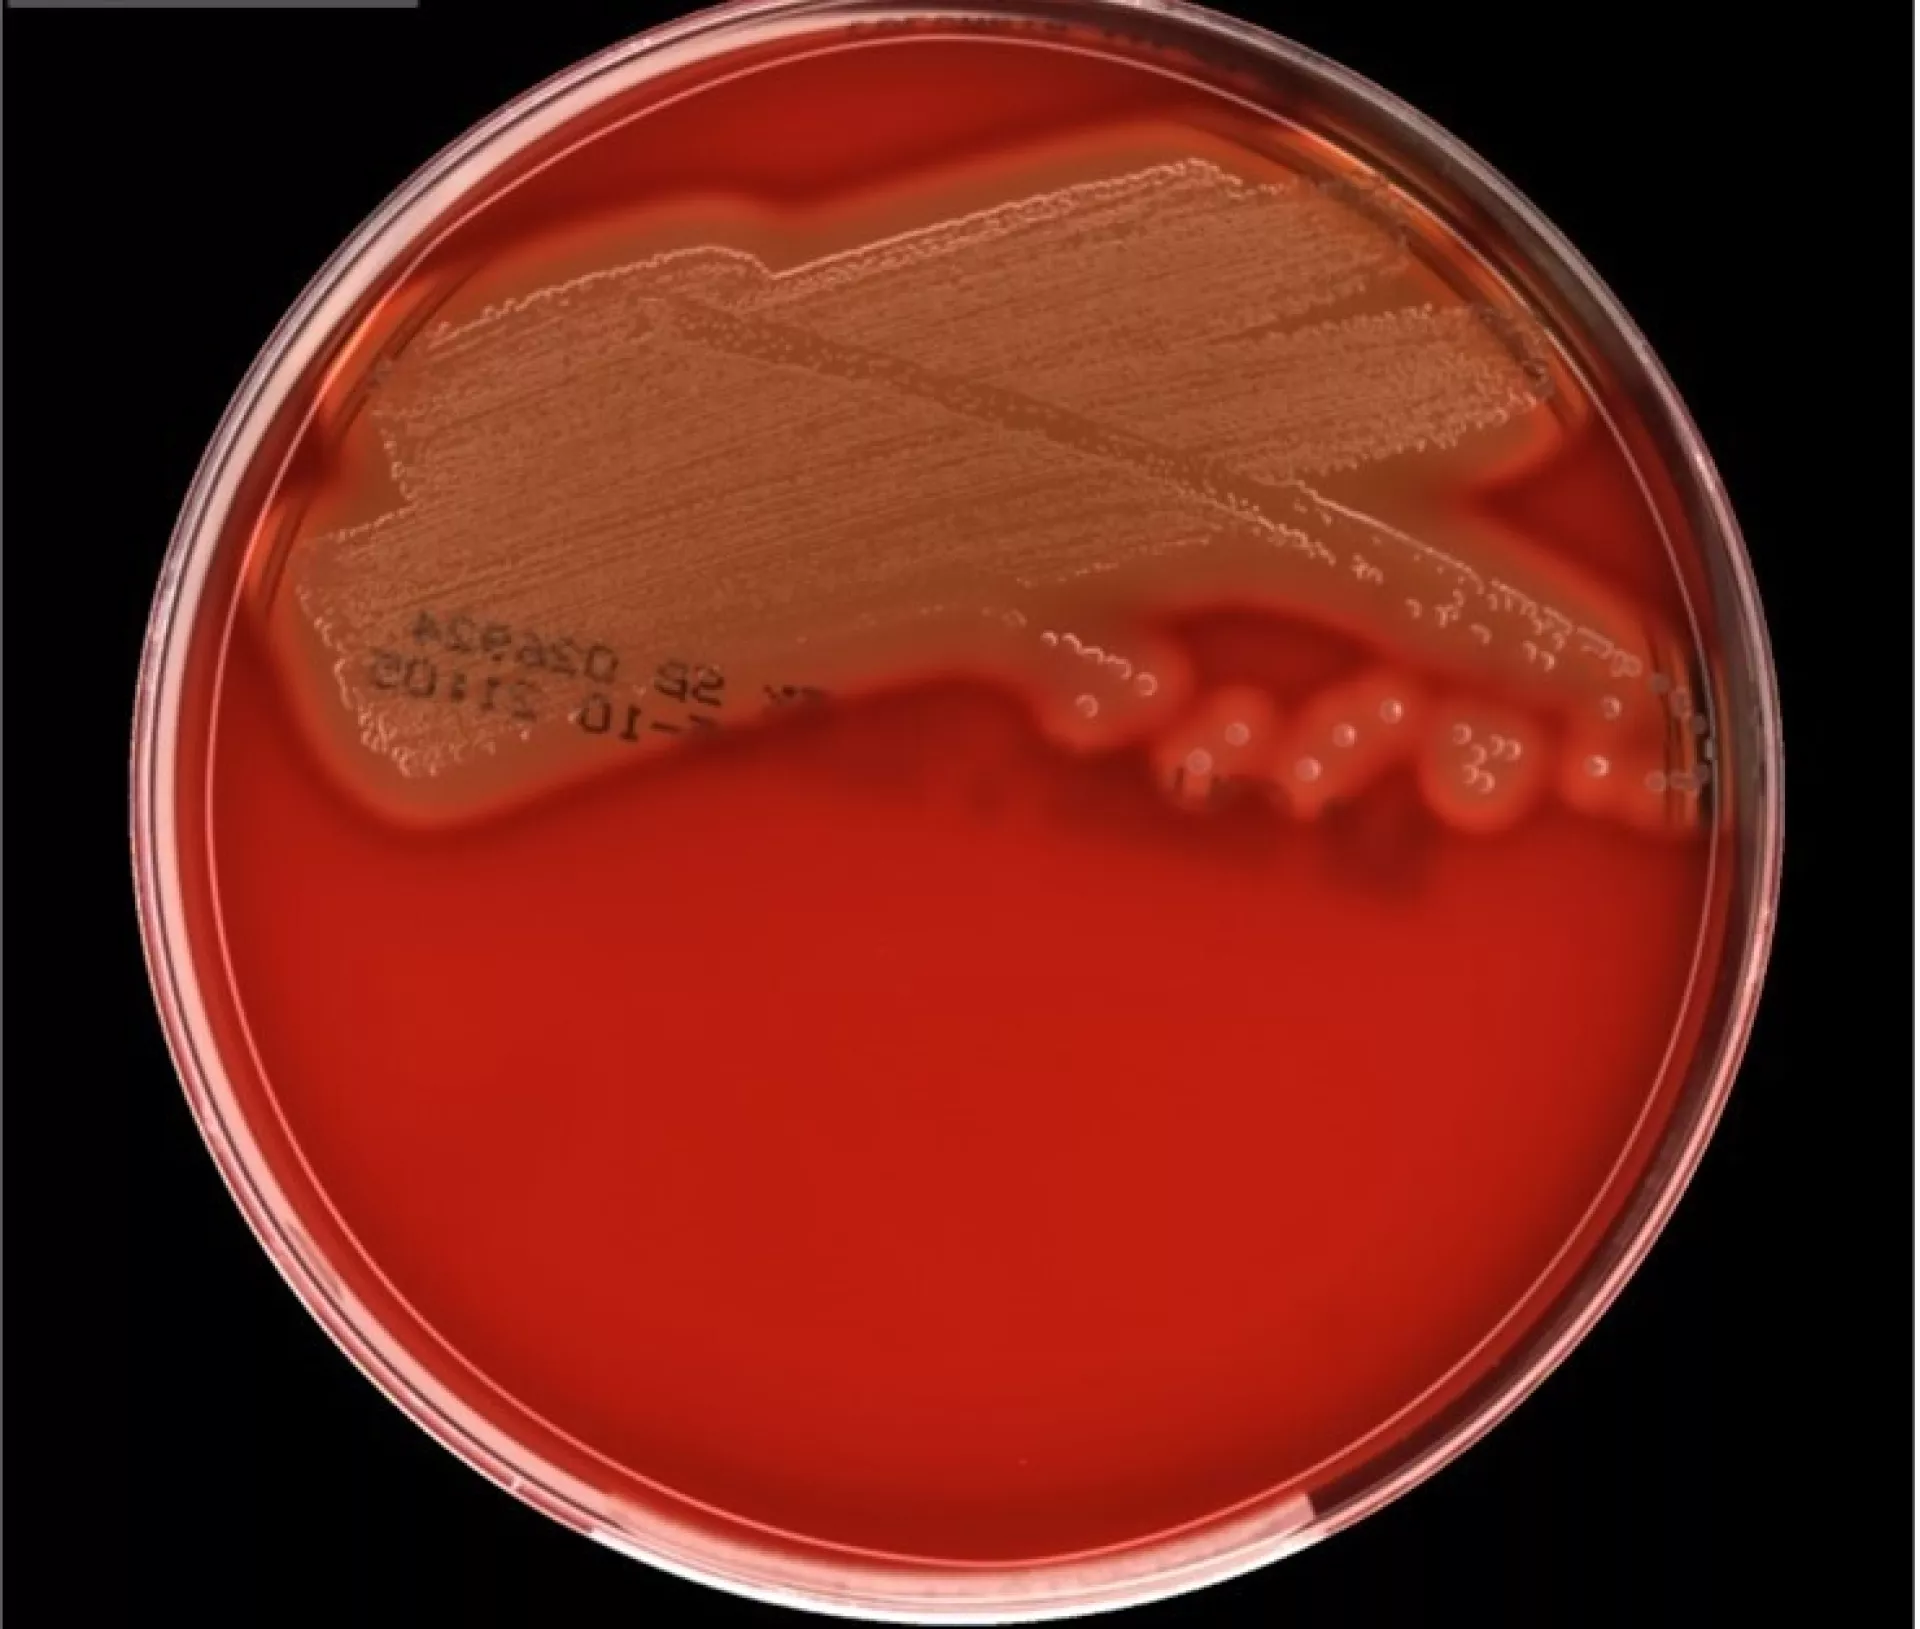
Streptokok op voedingsbodem

Analist Medische Microbiologie
Akkelyn Bouma | Analist Medische Microbiologie (Bacteriologie)
Op 15 april is de dag van de analist. De term analist is een breed begrip. Zo zijn er data-analisten, business analisten of politieke analisten, maar ook analisten die een bepaalde sport analyseren. Deze dag gaat echter over analisten in de laboratoriumwereld. In het kader daarvan wil ik het graag specifiek met jullie hebben over de analisten die werkzaam zijn binnen de Medische Microbiologie.
Als analist Medische Microbiologie kan je op drie verschillende afdelingen werken, Bacteriologie, Moleculair of Immunodiagnostiek. Zoals de term microbiologie al aangeeft houden deze analisten zich bezig met micro-organismen die infectie ziekten kunnen veroorzaken bij de mens.
Bijna wekelijks springen de micro-organismen er wel uit in een artikel of nieuwsitem. Doorgaans zijn dit zorgwekkende berichten. Zo stond er afgelopen week een bericht over de potentieel dodelijke Candida auris. Heel af en toe komen de micro-organismen ook op een andere manier in het nieuws: zo is er ongeveer 200 jaar na de dood van componist Beethoven DNA onderzoek verricht op een bewaarde haar van de componist. Hieruit blijkt dat de componist de laatste maanden voor zijn dood leed aan een infectie met het hepatitis B-virus. Het mooie van dit item vond ik dat mijn werk als analist hier samenkomt met mijn interesse voor de klassieke muziek als musicus.

Ziekteverwekkers
Als analisten houden we ons dus bezig met de zoektocht naar pathogene (ziekteverwekkende) micro-organismen (zoals bacteriën, schimmels, parasieten of virussen) bij de mens. Een patiënt komt bij de huisarts of specialist met een zorgvraag. Als de oorzaak gezocht wordt in een pathogeen micro-organisme, kan de specialist materiaal van de patiënt opsturen naar Certe. Dit kan bijvoorbeeld urine, sputum, een bloedkweek, prothesemateriaal of een wonduitstrijk zijn. Als het materiaal bij ons binnenkomt kan er op verschillende manieren gezocht worden naar de ziekteverwekker: met behulp van een kweek, antigeen- /antistofreactie of op DNA-niveau met behulp van een PCR-test.
Op kweek
Op de afdeling Bacteriologie, waar ik zelf werkzaam ben, gaan we op zoek naar de verwekker met behulp van een kweek. Hoe dit proces in zijn werk gaat hoop ik te verduidelijken met het volgende voorbeeld. Wanneer een patiënt bij de huisarts komt met een urineweginfectie, kan de huisarts ervoor kiezen om urine op te sturen voor onderzoek. Op de afdeling Bacteriologie wordt de urine op kweek gezet. Met het blote oog is één bacterie niet te zien, dus moet de bacterie eerst vermenigvuldigen. Dit gebeurt overnacht in de stoof bij 37°C. De volgende ochtend beoordeelt de analist of er iets is gaan groeien en of het pathogeen is. Wanneer er een pathogene bacterie groeit, bepalen we om welke bacterie het gaat en voeren we vervolgens een gevoeligheidsbepaling uit. Hierbij kijken we welke antibiotica gevoelig is om de klachten die de patiënt heeft te behandelen. Deze uitslag wordt vervolgens gecommuniceerd naar de aanvrager, waarna de patiënt behandeld kan worden.
Van levensbelang
Ik sluit graag af met een interessante casus. Kortgeleden kregen wij een oor uitstrijk binnen van een dame op leeftijd die opgenomen was in het ziekenhuis met veel oorpijn. De KNO-arts dacht aan otitis media acuta met perforatie trommelvlies. De volgende dag liet de kweek een Groep A-streptokok zien. Kort daarop kregen wij ook bloedkweken van deze dame binnen en in de kweek groeide ook een Groep A-streptokok. Zo snel kan het gaan, wat begint met oorpijn kan uiteindelijk een bloedvergiftiging ook wel sepsis genoemd veroorzaken. De Groep A-streptokok kennen we in de volksmond ook als de ‘vleesetende bacterie’. Er zijn twee soorten Groep A-streptokok infecties. De niet-invasieve infecties deze verlopen doorgaans mild. Daarnaast heb je de invasieve infecties, hierbij kan de bacterie in de bloedbaan terechtkomen. Zoals ook bij onze dame in kwestie het geval was. Deze bacterie springt er de laatste tijd zorgwekkend veel uit in de media. Sinds het voorjaar van 2022 is er een stijging gezien in de hoeveelheid Groep A-streptokokken die gekweekt zijn in vergelijking met eerdere jaren. Ook in januari en februari van dit jaar zijn er opmerkelijk veel Groep A-streptokokken gekweekt. Met de juiste behandeling is voor de dame de weg naar herstel ingezet.
Zoals jullie kunnen lezen is het werk van een analist ontzettend interessant en afwisselend. Die kleine beestjes kunnen ons behoorlijk op het verkeerde been zetten en ze blijven ons verrassen! Ik hoop dat ik met behulp van mijn verhaal jullie heb kunnen laten zien hoe leuk ons werk is. Het allerleukst vind ik om het vak over te dragen en uitleg te geven wat wij zoal doen. Dus mocht je meer willen weten over deze verbluffende micro-wereld dan vertel ik je met enthousiasme meer over dit vakgebied!